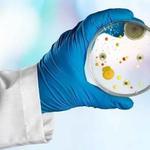

Mold Inspection911
About Business
Mold Inspection911 specializes in mold testing for both residential and commercial buildings. We are very unique in that we do not do any mold removal, which eliminates the potential conflicts of interest that have plagued our industry for so long. It is our focus to provide our clients with that unbiased third party opinion so that they can move forward with confidence and security in the decisions they make. We strive to offer expedited service to all of our clients without charging an arm and a leg above and beyond our standard rates and have done so for the past 28 years and will continue to do our very best to remain better than competitive for the various types of testing procedures necessary when a mold concern exists.
Other Businesses

Home Inspectors
Inspection Plus LTD

Home Inspectors
PPPI Au

Home Inspectors
The Hub City Mold Inspection

Home Inspectors
Bean Bags Dubai

Home Inspectors
Evergreen State Mold Inspection

Home Inspectors
Trusted House Services LLC

Home Inspectors
Property Pros Home Inspections

Home Inspectors